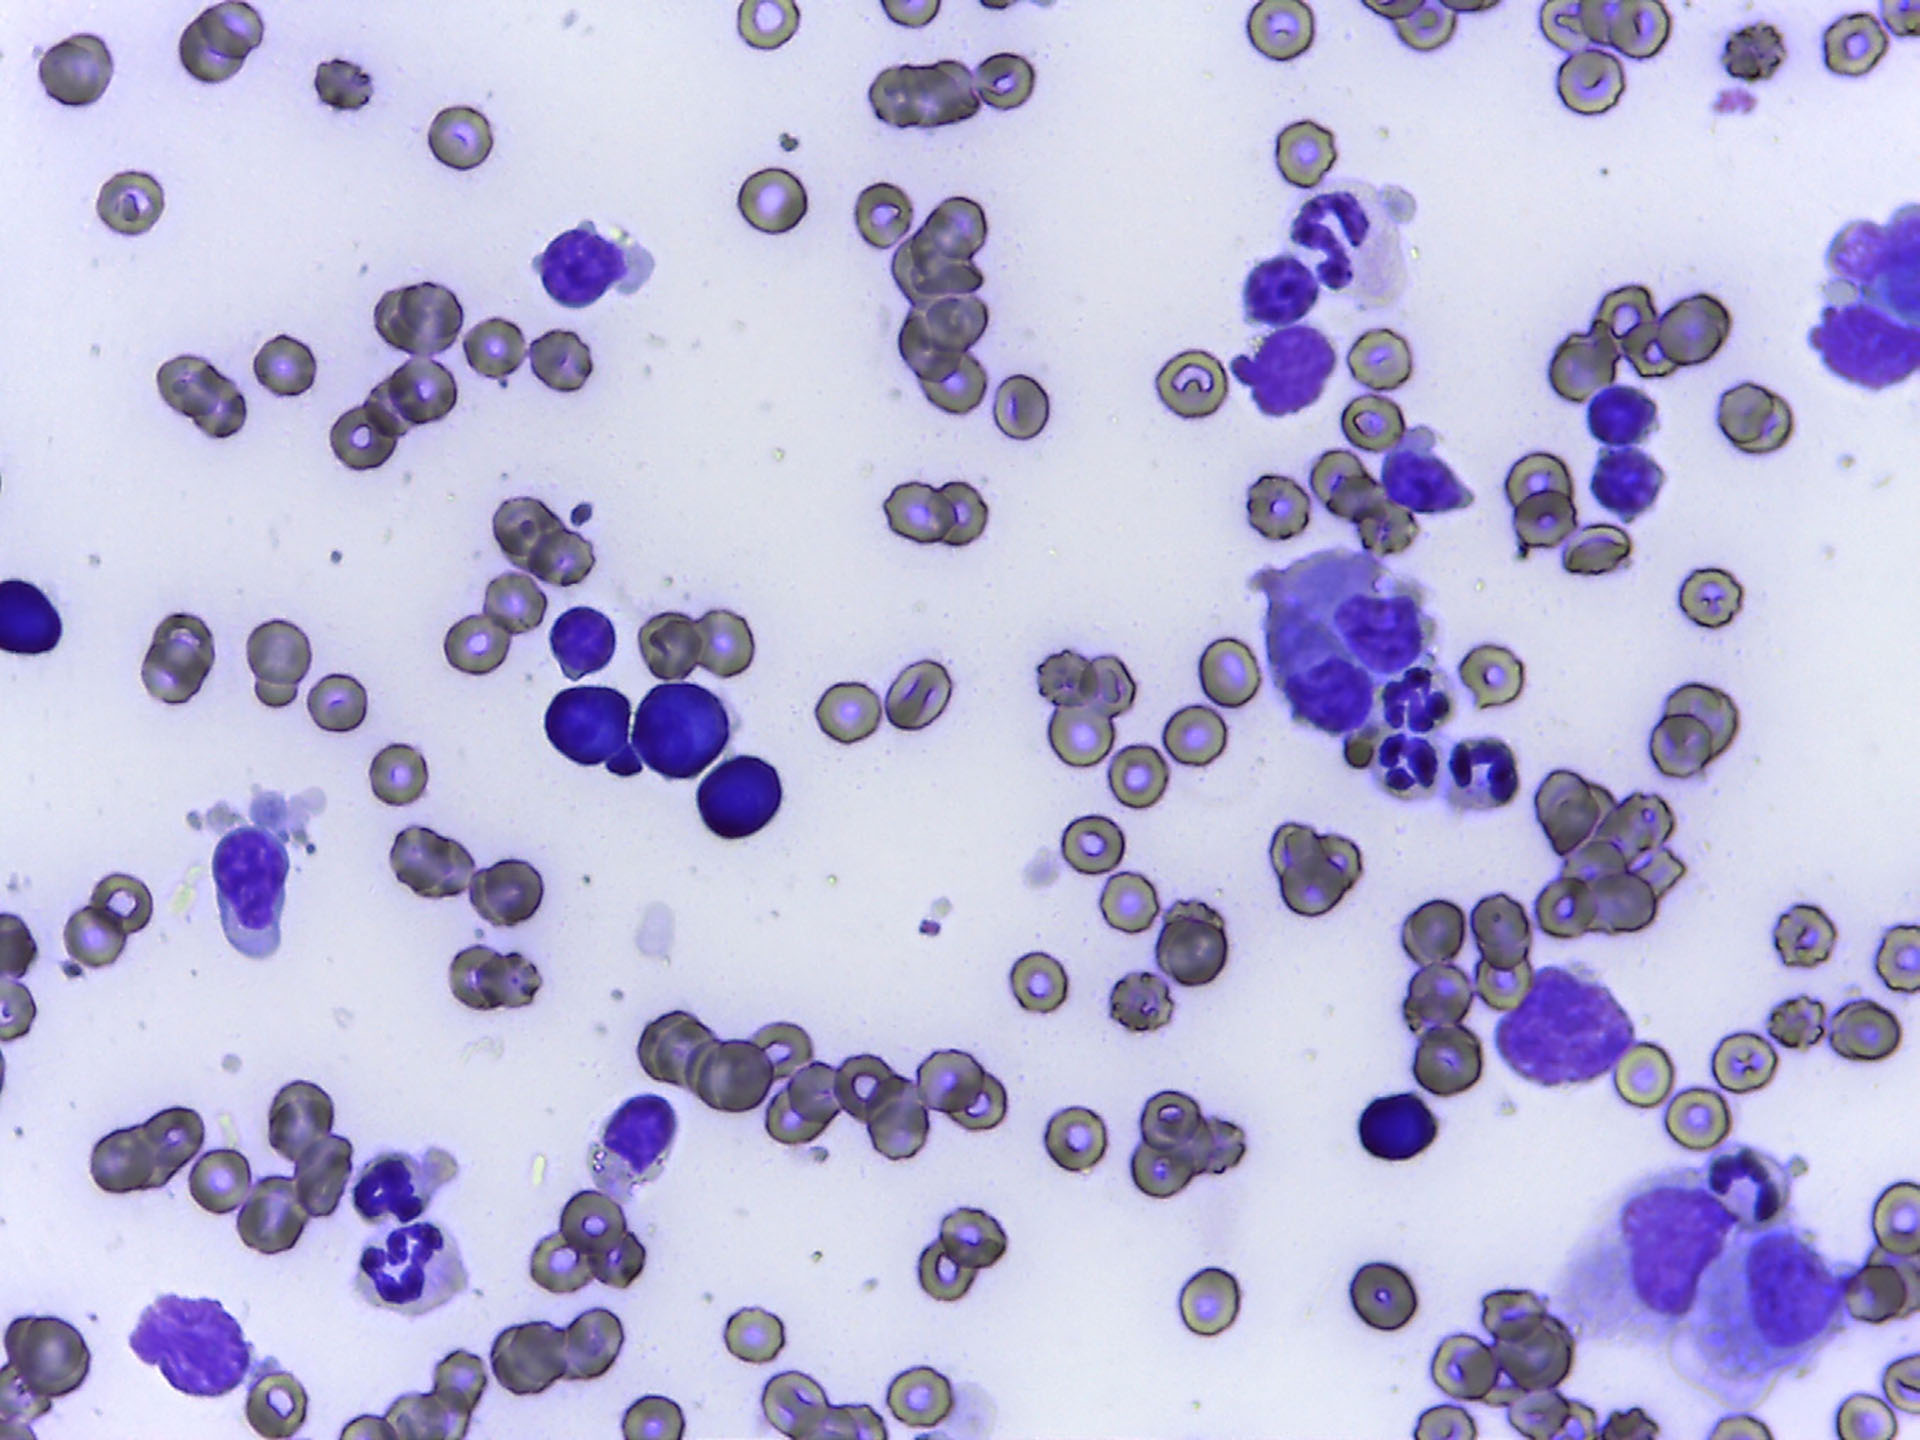

Steroidresponsiv mesenteriell lymfadenitt sannsynlig sekundært til tularemi-infeksjon hos hund
Tularemi, forårsaket av bakterien Francisella tularensis forekommer ofte som en selvbegrensende infeksjon hos hunder. Denne artikkelen beskriver to hunder som utviklet en alvorlig bakteriell infeksjon som trolig utløste en sekundær, steroidresponsiv mesenteriell lymfadenitt etter kontakt med hare. Steroidresponsiv mesenteriell lymfadenitt er ikke tidligere beskrevet som en konsekvens av tularemi-infeksjon hos hund. Kasuistikkene belyser utfordringer ved diagnostikk og behandling av tularemi hos hund, samt mulige immunmedierte mekanismer som kan påvirke både sykdomsforløp og terapivalg.
Spesialist i smådyrsykdommer - hund og katt, Fredrikstad Dyrehospital
Spesialist i smådyrsykdommer - hund og katt, Fredrikstad Dyrehospital
Innledning
Tularemi er en zoonotisk bakterieinfeksjon forårsaket av Francisella tularensis, der den mindre virulente F. tularensis ssp. holarctica (Type B) dominerer smitte på den nordlige halvkulen, mens den mer virulente F. tularensis ssp. tularensis (Type A) dominerer i Nord-Amerika (1).
Smitte skjer vanligvis via kontakt med infiserte gnagere eller kaniner, eller gjennom vektorer som flått og hjortefluer. Selv om hunder anses som relativt resistente er det dokumentert tilfeller med kliniske sykdomstegn som feber, letargi, anoreksi og lymfadenopati. Infeksjonen er ofte selvbegrensende (2).
Forfatterne er ikke kjent med at steroidresponsiv mesenteriell lymfadenitt er beskrevet sekundært til tularemi-infeksjon hos hund.
Denne artikkelen omfatter to hunder med lignende sykdomsforløp, den ene (Kasuistikk 1) etter kontakt med en død hare og den andre (Kasuistikk 2) etter drivjakt med eksponering for tularemi-smitte.
Kasuistikk 1
Signalement og anamnese
En border collie, intakt tispe, 2 år gammel med kroppsvekt 13 kg var henvist fra en annen klinikk. Hunden viste første gang kliniske tegn på sykdom høsten 2023 med nedsatt allmenntilstand, anoreksi og feber (40,9 °C). Eier fortalte at hunden hadde hatt nærkontakt med en død hare to uker før hunden ble syk.
Klinisk undersøkelse
Hunden fremsto som svært medtatt og slapp. Hjertefrekvensen var 70 slag/min., uanstrengt kostoabdominal respirasjon med respirasjonsfrekvens på 28 per min., rosa, fuktige slimhinner og en rektaltemperatur på 40,0 °C. Palpasjon av perifere lymfeknuter var uten avvik. Tispa viste mildt ubehag ved bukpalpasjon og det kunne palperes en avlang, fast struktur sentralt i buken.
Diagnostiske undersøkelser
Blodanalyser
Hematologiske analyser viste en mild, non-regenerativ anemi, leukocytose med mild nøytrofili, mild monocytose og mild eosinofili. CRP var høy, 99 mg/L (RI: 0-10 mg/L). Biokjemiske analyser inkludert elektrolytter var uten avvik. Hunden testet negativ for leptospirose, borreliose, anaplasma, ehrlichia og dirofilaria. Serum ble sendt til eksternt laboratorium for å måle antistoffer mot tularemi.
Ultralydundersøkelse av buken

Figur 1. Ultralyd av en forstørret og hypoekkogen mesenteriell lymfeknute med bredde 14,4 mm (gule kryss) og parenkymale anekkogene foci (gule piler).
Foto: Maria Hære
Det ble funnet forstørrede mesenterielle lymfeknuter som viste seg å være strukturen som kunne kjennes ved bukpalpasjon. De mesenterielle lymfeknutene (Figur 1) målte opp mot 14,4 mm i bredden (Ref .< 8 mm), var heterogene med hypo- til anekkogene foci i parenkymet, og med hyperekkogent omkringliggende krøs forenlig med fokal reaksjon. Ileum hadde fortykket tarmvegg, målt til 5,7 mm (Ref. 2-4 mm). Milten ble vurdert som forstørret og med et noe grovt parenkym. Resterende tarm og bukorganer ble vurdert som normale.
Finnålsaspirat mesenterielle lymfeknuter

Figur 2. FNA fra anekkogen foci i mesenteriell lymfeknute viste overveiende forekomst av ikke-degenererte nøytrofile granulocytter mot en basofil bakgrunn. Det er mild grad av blodkontaminasjon.
Foto: Maria Hære
Det ble funnet overveiende nøytrofile granulocytter fra anekkogene foci i lymfeknuter (Figur 2), forenlig med lymfadenitt. Aspirat tatt fra mer ekkogene partier viste modne lymfocytter forenlig med en reaktiv lymfeknute.
Behandling og forløp
Basert på sterk mistanke om tularemi ble det igangsatt behandling med doksycyklin 5 mg/kg BID (1) i påvente av prøvesvar på tularemi-titer. Ytterligere behandling besto av 15 mg/kg paracetamol IV q8h grunnet feber og buksmerter, og 1 mg/kg maropitant SC q24h som antiemetika. Grunnet feber ble hunden også behandlet med Ringer Acetat som kontinuerlig infusjon med en innledende væskehastighet på 3 mL/kg/time. Hunden viste ingen bedring i løpet av to døgn, hadde fortsatt høy feber med 40,4 °C og alvorlig nedsatt allmenntilstand.
Hunden testet positivt for tularemi med et titer på 40 (positivt titer: >5), basert på mikroagglutinasjonstest for antistoffer i serum. På grunn av mistanke om sekundær immunmediert lymfadenitt ble hunden gitt 0,2 mg/kg deksametason IV. Hunden viste deretter rask klinisk bedring og var afebril i løpet av få timer.
Hunden ble videre behandlet med immundempende doser 2 mg/kg prednisolon q24h. Ved gjentatte forsøk på å senke dosen over de neste ukene fikk hunden tilbakefall i form av feber og buksmerter. Langsom nedtrapping av kortisondosen over flere måneder var nødvendig for å unngå tilbakefall. Ved gjentatt analyse av tularemi-titer to uker senere var denne sunket til 10 (positivt titer: >5).
Kasuistikk 2
Signalement og anamnese
En drever, intakt hannhund, 3 år gammel med kroppsvekt 19 kg var henvist fra en annen klinikk. Hunden utviklet kliniske sykdomstegn første gang i starten av november 2022. Hunden ble beskrevet av eier til å ha redusert allmenntilstand, anoreksi, et fåtall episoder med oppkast og feber (40,7 °C). Hjemme syns eier hunden hadde pustet litt tyngre enn vanlig. Eier var jeger, og hunden hadde relativt nylig vært på drivjakt.
Klinisk undersøkelse
Hunden var sløv og alvorlig nedstemt, men ambulatorisk. Hjertefrekvensen var 100 slag/min., med synkron og normodynamisk puls. Hunden hadde mild takypné og lett økte lungelyder ved auskultasjon. Munnslimhinnen var rosa og varm, med kapillærfylningstid på 2 sek. De perifere lymfeknutene var normalstore, symmetriske og med normal konsistens. Ved abdominal palpasjon viste hunden tegn på ubehag, og det ble palpert klumpete strukturer i midtre-til kraniale buk. Rektaltemperatur ble målt til 39,2 °C. Hunden hadde blitt behandlet med ukjent dose av buprenorfin og 3. generasjons cefalosporin av henvisende veterinær samme dag.
Diagnostiske undersøkelser
Blodanalyser
Blodprøver viste en mild mikrocytær hypokrom non-regenerativ anemi, uttalt leukocytose med nøytrofili, monocytose og eosinopeni. CRP var høy, 95,9 mg/L (RI: 0-10). Det var ingen avvik på de biokjemiske analysene, og alle elektrolytter var innenfor referanseintervallene. Serum ble sendt til eksternt laboratorium for å måle antistoffer mot tularemi.
Ultralydundersøkelse av abdomen

Figur 3. Ultralyd av en hypoekkogen og svært forstørret mesenteriell lymfeknute (avgrenset med gule piler).
Foto: Maria Hære
Ultralyd avdekket enorme mesenterielle lymfeknuter distribuert på en slik måte at de knapt kunne skilles fra hverandre (Figur 3). Alle lymfeknutene var heterogene med hypo- til anekkogene foci i parenkymet. Det var små anekkogene væskelommer i det ellers hyperekkogene omkringliggende krøset, samt kranialt for urinblæren. Resterende bukorganer, hadde normalt ultrasonografisk utseende.
Røntgenundersøkelse av lunger

Figur 4. Røntgen av thorax i venstre sideplan. Tydelig multifokale opasiteter (røde stjerner) i dorsokraniale og ventrokaudale lungefelt.
Foto: Empet Halden Dyreklinikk
Det ble sett fokale, flekkete fortetninger diffust fordelt dorsokranialt i lungefeltet i venstre sideplan (Figur 4), samt perihilært i området for de bronkiale lymfeknutene.
Finnålsaspirat fra mesenterielle lymfeknuter
Figur 5. FNA fra mesenteriell lymfeknute med økt forekomst av ikke-degenererte nøytrofile granulocytter og mild forekomst av makrofager. Det er mild grad av blodkontaminasjon.
Foto: Maria Hære
Cellepopulasjonen var primært granulocytær med overveiende forekomst av nøytrofile granulocytter med milde degenerative trekk, og noen makrofager (Figur 5). Det ble ikke funnet bakterier. Funnene var forenlig med lymfadenitt, noe som ble bekreftet med ekstern cytologisk evaluering av finnålsprøvene.
Behandling og forløp
Mistanken om tularemi var sterk. I påvente av prøvesvar for tularemi-titer ble det igangsatt behandling med 5 mg/kg doksycyklin BID i henhold til antibiotikaanbefaling ved tularemi hos hund (1). Hunden ble innlagt på dyrehospitalet og behandlet med Ringer Acetat iv med en innledende væskehastighet på 3 mL/kg/t grunnet feber. Det ble administrert 10 mg/kg paracetamol PO q8h grunnet feber og buksmerter og 1 mg/kg maropitant SC q24h grunnet historikk med oppkast. Da hunden ikke viste bedring i allmenntilstanden og fortsatt hadde feber, ble det gitt immundempende dose 2 mg/kg prednisolon PO q24h. En primær immunmediert lymfadenitt var ikke utelukket på dette tidspunktet. Hunden viste stor bedring i allmenntilstand og var afebril i løpet av natten.
Hunden testet positivt for tularemi med et titer på 160 (positivt titer: >5), basert på mikroagglutinasjonstest for antistoffer i serum. Etter påvisning av høyt tularemi-titer ble det forsøkt nedtrapping av prednisolon i flere omganger, med tilbakefall av kliniske sykdomstegn hver gang. Ved gjentatt analyse av tularemititer cirka 4 uker senere var denne sunket til 80 (positivt titer: >5).
Diskusjon
Tularemi er en zoonotisk sykdom forårsaket av Francisella tularensis. F. tularensis ssp. tularensis (type A) har størst grad av virulens for mennesker og dominerer i Nord-Amerika, mens den mindre virulente underarten F. tularensis spp. holarctica (type B) dominerer i Europa og Asia (3).
Smitte med F. tularensis skjer ved kontakt med infiserte dyr, flått- eller hjortelusbitt og innånding eller inntak av bakterien (1). Jakthunder i endemiske områder er mer utsatt for direkte smitte grunnet nærkontakt med harer eller andre naturlige reservoarer fra ordenene Lagomorpha eller Rodentia, der for eksempel lemmen utgjør en kilde til naturlig infeksjon i Norge.
Hunder og katter anses som relativt motstandsdyktige mot bakterien, og infeksjon med F. tularensis spp. holarctica er ofte selvbegrensende med uspesifikke kliniske tegn som pyreksi, letargi og anoreksi. Lymfadenopati, oppkast, diaré, mukopurulent okulonasal utflod og hudlesjoner er rapportert i mer alvorlige tilfeller (2). Hos mer tularemisensitive dyr, som harer, ses ofte uttalt letargi etterfulgt av fatal septikemi og død innen 2-10 dager (4).
De to hundene beskrevet i disse kasuistikkene hadde svært like kliniske tegn og forløp hvor begge hundene mistenktes å ha utviklet tularemi etter direkte kontakt med en død hare. En sikker tularemi-diagnose ekstrapolert fra humanmedisin stilles ideelt sett basert på stigende titer i parprøver tatt med 2-4 ukers mellomrom (5), i motsetning til synkende titer som hos disse pasientene. Bakterieinfeksjonen i seg selv har sannsynligvis vært selvbegrensende, men en sekundær og sannsynlig steroidresponsiv lymfadenitt har forårsaket alvorlig systemisk sykdom. Dette kan også forklare hvorfor parprøvene fra begge pasientene viste synkende fremfor stigende titer – hundene har ikke blitt opplevd som syke når antistofftiteret har vært høyest, og har derfor heller ikke vært hos veterinær. Begge pasientene ble henvist til Fredrikstad Dyrehospital først 3-4 uker etter smitteksponeringen.
Det finnes oss bekjent ingen evidens for bruk av kortikosteroider i primærbehandlingen av tularemi, men det virker sannsynlig at den sekundære lymfadenitten vi antok utviklet seg i etterkant av tularemi-infeksjonen indiserte kortikosteroidbehandling. Hos hunden i Kasuistikk 2 var det ingen bedring av sykdomstegn før kortikosteroider ble startet forholdsvis langt ut i sykdomsforløpet. I denne perioden hadde hunden blitt behandlet med flere typer antibiotika, uten synlig effekt. Hos begge hundene ble både antiinflammatoriske (0,5-1,0 mg/kg) og immundempende (2,0 mg/kg) doser prednisolon forsøkt, der rask nedtitrering til antiinflammatorisk dose var assosiert med tilbakefall av alvorlige sykdomstegn i løpet av 24 timer.
Doksycyklin er beskrevet som førstevalg ved behandling av tularemi hos hunder (1). Ingen av de to pasientene beskrevet i disse kasuistikkene hadde tilstrekkelig effekt av doksycyklin, og det ble byttet til enrofloksacin da dette preparatet er førstevalget ved behandling av moderate tularemi-infeksjoner hos mennesker, mens aminoglykosider er førstevalget ved alvorlige infeksjoner (6). I begge tilfellene ble bytte av antibiotika gjort et stykke ut i behandlingsforløpet, og dermed er det vanskelig å si om hundene responderte på – eller i det hele tatt hadde behov for antibiotika, eller om det kun var kortikosteroider som utgjorde effektiv behandling av pasientene. Flere bakterieinfeksjoner som kan ramme hunder kan være selvbegrensende og derfor sjeldent ha behov for antibiotikabehandling – eksempelvis akutt gastroenteritt forårsaket av Salmonella sp. eller Clostridium perfringens, eller kennelhoste forårsaket av Bordetella bronchiceptica. Kanskje gjelder det samme ved tularemi-infeksjon hos ellers immunkompetente hunder. I behandlingen av Yersinia pestis, en bakterie med mange like egenskaper som F. tularensis, fører samtidig bruk av kortison og antibiotika til mer effektiv eliminering av bakterien (7).
Det er sannsynlig at pasientenes lymfadenitt var immunmediert basert på den nødvendige og langvarige behandlingen med kortison, og mangelfulle responsen på antibiotika. Tilstanden steril steroidresponsiv lymfadenitt beskrevet spesielt hos engelsk springer spaniel er antatt å forekomme til dels som følge av en type IV immunopatologisk reaksjon. Reaksjonen kjennetegnes av en cellemediert immunrespons der vedvarende T-celle og makrofag-stimulering forårsaker nøytrofil eller pyogranulomatøs inflammasjon spesielt i lymfeknuter, lunger og hud som respons på kronisk antigenstimulering (8,9). Det er derfor nærliggende å anta at en liknende mekanisme forårsaket lymfadenitt i disse pasientene. En annen mulig mekanisme for utvikling av sekundær lymfadenitt i disse hundene er type II immunopatologiske reaksjoner (10) som ses ved immunmediert hemolytisk anemi (IMHA), steroidresponsiv meningitt-arteritt (SRMA), immunmediert polyartritt (IMPA) og immunmediert trombocytopeni (ITP). Denne typen kjennetegnes av komplementfiksering og aktivering av NK-celler og andre fagocytterende celler, stimulert av celle-assosierte antigener eller celleoverflateantigener. De viktigste immunoglobulinene i type II reaksjoner er IgG og IgM (11). Både type II og type IV-immunopatologiske reaksjoner krever immunsuppressiv og/eller immunmodulerende behandling. Begge hundene i disse kasuistikkene hadde lokal mesenteriell lymfadenopati uten affeksjon av viscerale eller perifere lymfeknuter som kunne reflektere en respons på peroralt inntak av bakterien. Hunden i Kasuistikk 2 hadde også patologiske forandringer i thorax, som kunne indikere kombinert peroral- og inhalasjonssmitte hos denne hunden.
Vi mistenker at det er en sammenheng mellom tularemi og påfølgende steroidresponsiv lymfadenitt hos disse to hundene og foreslår at screening for tularami bør overveies hos hunder med steroidresponsiv lymfadenitt.
Sammendrag
Tularemi er en zoonotisk sykdom forårsaket av bakterien Francisella tularensis, hvor type B (holarctica) er vanligst i Europa. Hunder kan smittes ved kontakt med infiserte harer, og tilstanden er ofte mild og selvbegrensende. Denne artikkelen beskriver to hunder som utviklet alvorlig steroidresponsiv lymfadenitt etter Tularemismitte. Effekten av antibiotika hos disse pasientene var ikke tilfredsstillende, derimot viste begge hunder bedring ved bruk av kortison i immundempende dose. Vi mistenker at begge hunder utviklet en sekundær immunmediert reaksjon etter tularemi-infeksjon, muligens type II hypersensitivitet. Vi foreslår screening for tularemi hos hunder med steroidresponsiv lymfadenitt.
Summary
Tularemia is a zoonotic disease caused by the bacterium Francisella tularensis, with type B (holarctica) being most common in Europe. Dogs can become infected through contact with infected hares, but the disease is often mild and self-limiting. In the two case reports described here, the dogs developed severe steroidresponsive lymphadenitis following a tularemia infection. The effectiveness of antibiotics in these patients was questionable, however, both dogs showed marked improvement when given steroids. We suspect that both dogs developed a secondary immunemediated reaction after tularemia infection, possibly type II hypersensitivity. We propose that screening for tularemia should be considered in dogs with steroidresponsive lymphadenitis.
Referanser
Sykes J, Greene C. Tularemia. I: Infectious diseases of the dog and cat. 4th ed. St.Louis, Missouri: Elsevier, 2012:476-84.
Kwit NA, Middaugh NA, VinHatton ES, Melman SD, Onischuk L, Aragon AS et al. Francisella tularensis infection in dogs: 88 cases (2014–2016). J Am Vet Med Assoc 2020;256:220-25.
Hestvik G, Warns-Petit E, Smith LA, Fox NJ, Uhlhorn H, Artois M et al. The status of tularemia in Europe in a one-health con a review. Epidemiol Infect 2015;143:2137-60.
World Organisation for Animal Health. Tularemia. I: WOAH terrestrial manual. Paris 2022. https://www.woah.org/fileadmin/Home/fr/Health_standards/tahm/3.01.23_TULAREMIA.pdf (10.11.2025).
Maurin M. Francisella tularensis, tularemia and serological diagnosis. Front Cell Infect Microbiol 2020;10:512090.
Maurin M, Pondérand L, Hennebique A, Pelloux I, Boisset S, Caspar Y. Tularemia treatment: experimental and clinical data. Front Microbiol 2024;14:1348323.
Levy Y, Vagima Y, Tidhar A, Zauberman A, Aftalion M, Gur D et al. Adjunctive corticosteroid treatment against Yersinia pestis improves bacterial clearance, immunopathology, and survival in the mouse model of bubonic plague. J Infect Dis 2016;214:970-7.
Bexfield N, Myatt P, Gajanayake I. Study into sterile neutrophilic-macrophagic lymphadenitis in the English springer spaniel. Vet Rec 2015;177:104.
Ribas Latre A, McPartland A, Cain D, Walker D, Black V, Van Den Steen N et al. Canine sterile steroidresponsive lymphadenitis in 49 dogs. J Small Anim Pract 2019;60:280-90.
Tizard I. Innate lymphoid cells. I: Veterinary immunology. 10th ed. St.Louis, Missouri: Elsevier, 2018:576-603.
Day M. Immunopathological mechanisms. Type II sensitivity. I: Clinical immunology of the dog and cat. 2nd ed. New York: Manson Publishing, 2012:66-7.